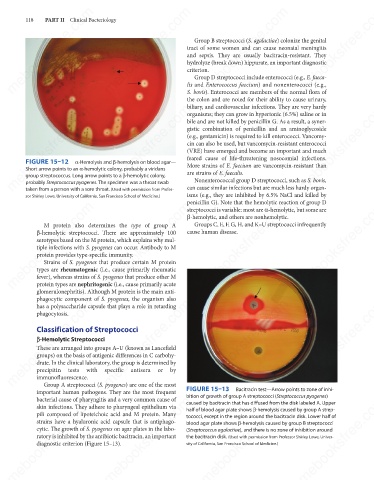

Page 129 - Review of Medical Microbiology and Immunology ( PDFDrive )
P. 129
mebooksfree.com
mebooksfree.com
mebooksfree.com
mebooksfree.com
mebooksfree.com
mebooksfree.com
mebooksfree.com
mebooksfree.com mebooksfree.com mebooksfree.com tract of some women and can cause neonatal meningitis mebooksfree.com
mebooksfree.com
PART II Clinical Bacteriology
118
Group B streptococci (S. agalactiae) colonize the genital
and sepsis. They are usually bacitracin-resistant. They
hydrolyze (break down) hippurate, an important diagnostic
criterion.
Group D streptococci include enterococci (e.g., E. faeca-
lis and Enterococcus faecium) and nonenterococci (e.g.,
S. bovis). Enterococci are members of the normal flora of
the colon and are noted for their ability to cause urinary,
biliary, and cardiovascular infections. They are very hardy
mebooksfree.com
mebooksfree.com mebooksfree.com mebooksfree.com gistic combination of penicillin and an aminoglycoside mebooksfree.com
mebooksfree.com
organisms; they can grow in hypertonic (6.5%) saline or in
bile and are not killed by penicillin G. As a result, a syner-
(e.g., gentamicin) is required to kill enterococci. Vancomy-
cin can also be used, but vancomycin-resistant enterococci
(VRE) have emerged and become an important and much
feared cause of life-threatening nosocomial infections.
FIGURE 15–12
α-Hemolysis and β-hemolysis on blood agar—
More strains of E. faecium are vancomycin-resistant than
Short arrow points to an α-hemolytic colony, probably a viridans
are strains of E. faecalis.
group streptococcus. Long arrow points to a β-hemolytic colony,
Nonenterococcal group D streptococci, such as S. bovis,
probably Streptococcus pyogenes. The specimen was a throat swab
taken from a person with a sore throat. (Used with permission from Profes-
isms (e.g., they are inhibited by 6.5% NaCl and killed by
sor Shirley Lowe, University of California, San Francisco School of Medicine.) can cause similar infections but are much less hardy organ-
penicillin G). Note that the hemolytic reaction of group D
mebooksfree.com mebooksfree.com mebooksfree.com cause human disease. mebooksfree.com mebooksfree.com
mebooksfree.com
streptococci is variable: most are α-hemolytic, but some are
β-hemolytic, and others are nonhemolytic.
Groups C, E, F, G, H, and K–U streptococci infrequently
M protein also determines the type of group A
β-hemolytic streptococci. There are approximately 100
serotypes based on the M protein, which explains why mul-
tiple infections with S. pyogenes can occur. Antibody to M
protein provides type-specific immunity.
Strains of S. pyogenes that produce certain M protein
types are rheumatogenic (i.e., cause primarily rheumatic
fever), whereas strains of S. pyogenes that produce other M
protein types are nephritogenic (i.e., cause primarily acute
glomerulonephritis). Although M protein is the main anti-
phagocytic component of S. pyogenes, the organism also
mebooksfree.com mebooksfree.com mebooksfree.com mebooksfree.com mebooksfree.com mebooksfree.com
has a polysaccharide capsule that plays a role in retarding
phagocytosis.
Classification of Streptococci
a-Hemolytic Streptococci
These are arranged into groups A–U (known as Lancefield
groups) on the basis of antigenic differences in C carbohy-
drate. In the clinical laboratory, the group is determined by
precipitin tests with specific antisera or by
immunofluorescence.
Group A streptococci (S. pyogenes) are one of the most
important human pathogens. They are the most frequent FIGURE 15–13 Bacitracin test—Arrow points to zone of inhi-
bition of growth of group A streptococci (Streptococcus pyogenes)
mebooksfree.com mebooksfree.com mebooksfree.com tococci, except in the region around the bacitracin disk. Lower half of mebooksfree.com
mebooksfree.com
mebooksfree.com
bacterial cause of pharyngitis and a very common cause of
caused by bacitracin that has diffused from the disk labeled A. Upper
skin infections. They adhere to pharyngeal epithelium via
half of blood agar plate shows β-hemolysis caused by group A strep-
pili composed of lipoteichoic acid and M protein. Many
strains have a hyaluronic acid capsule that is antiphago-
blood agar plate shows β-hemolysis caused by group B streptococci
cytic. The growth of S. pyogenes on agar plates in the labo-
(Streptococcus agalactiae), and there is no zone of inhibition around
ratory is inhibited by the antibiotic bacitracin, an important
the bacitracin disk. (Used with permission from Professor Shirley Lowe, Univer-
diagnostic criterion (Figure 15–13).
sity of California, San Francisco School of Medicine.)
mebooksfree.com mebooksfree.com mebooksfree.com mebooksfree.com mebooksfree.com mebooksfree.com